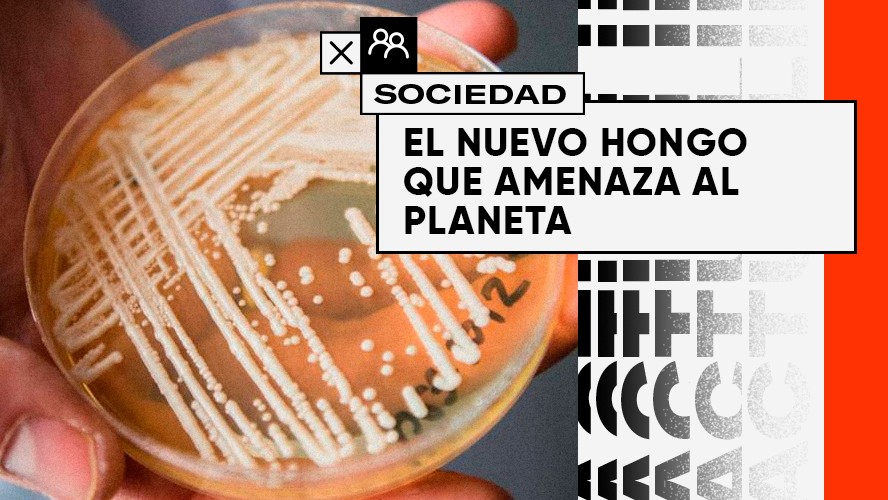
El nuevo hongo letal que amenaza a los humanos | Sociedad

Cuando, con la llegada de las vacunas, el mundo empieza a pensar en superar la pandemia de COVID-19, una nueva amenaza causa terror a los humanos: el Candida auris.
¿Qué es? Se trata de una especie de hongo aparecida en 2009 en Canadá que es una de las pocas que puede causarle a humanos la enfermedad de candidiasis, una infección viral que afecta la flora intestinal y la vagina, en el caso de las mujeres.
Un caso detectado en Brasil encendió las alarmas de nuestro país, es por eso que en Argentina ya funciona un equipo de trabajo para análisis y prevención, buscando evitar que llegue aquí el problema informado en el vecino país.
El microorganismo, que crece en forma de levadura, puede matar en 90 días y se contagia especialmente en hospitales. Hasta el momento, más de 30 países informaron infecciones con Candida auris.









